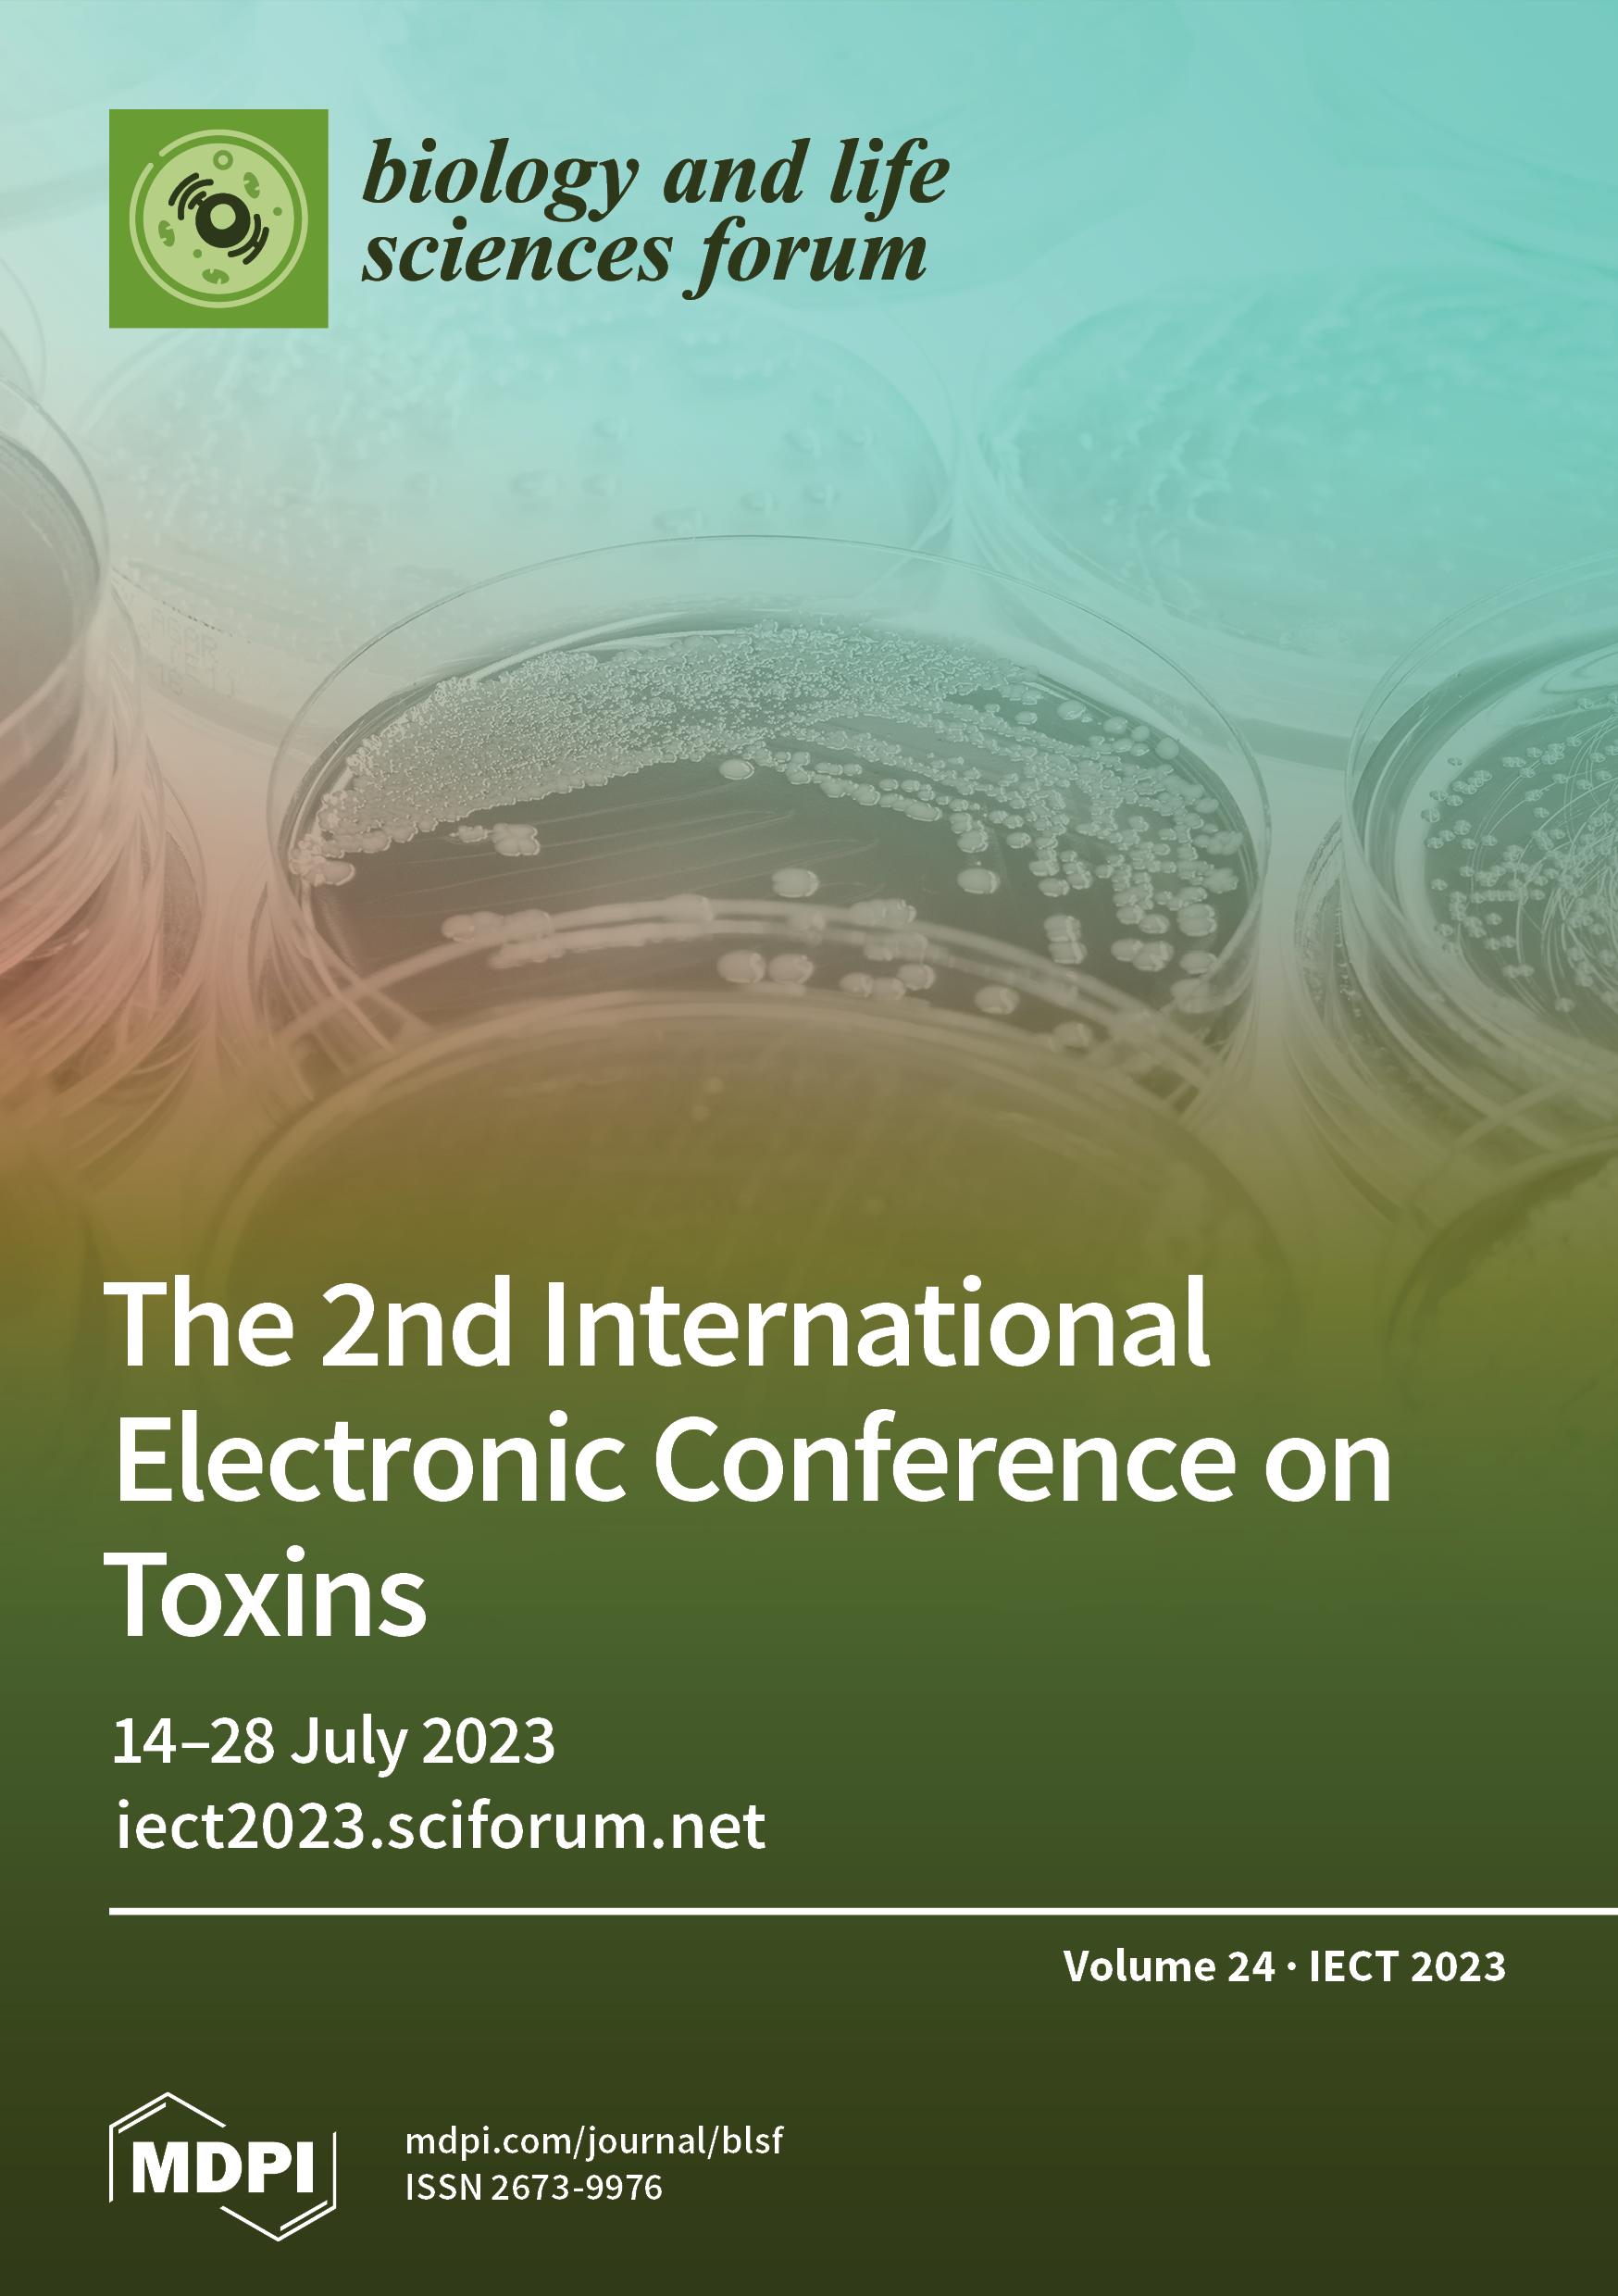
Volume 24, Issue 1

All Issues
ISSN 2673-9976
Volume 52 - Issue 1 IOCT 2025 2025

Vol. 52, Iss 1
IOCT 2025
ISSN 2673-9976
Volume 51 - Issue 1 IHCE 2025 2025

Vol. 51, Iss 1
IHCE 2025
ISSN 2673-9976
Volume 50 - Issue 1 ValSe & CICLA 2025 2025

Vol. 50, Iss 1
ValSe & CICLA 2025
of 2